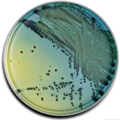
E-shop hlavní obrázek

Bujón Mueller-Hinton je tekuté živné médium, které se používá k testování antimikrobiální citlivosti aerobních a fakultativně anaerobních bakterií. Používá se jako kultivační médium k provedení testů antimikrobiální citlivosti diluční metodou (1, 2) a jako základní médium pro přípravu bakteriálního inokula.

Bujón Mueller-Hinton je tekuté živné médium, které se používá k testování antimikrobiální citlivosti aerobních a fakultativně anaerobních bakterií. Používá se jako kultivační médium a jako základní médium pro přípravu bakteriálního inokula.
Kultivační půda pro testování citlivosti na antibiotika a pro primární izolaci gonokoků a meningokoků a dalších patogenů z klinických vzorků. Tento produkt je dodáván v dehydratované formě a je určen pro přípravu hotových kultivačních médií.

Selektivně obohacovací médium pro salmonely.
Produkt je dodáván v dehydratované formě a je určen pro přípravu hotových kultivačních médií.

MIC Test stripy jsou určeny pro kvantitativní stanovení minimální inhibiční koncentrace (MIC) antimikrobiálních látek proti mikroorganismům a pro detekci mechanismů rezistence.

ELISA souprava je určená pro kvantitativní stanovení lidského Mixovirového proteinu A (MxA) v plné krvi .

Mycobiotic Agar je doporučen pro izolaci plísňových patogenů u vysoce kontaminovaných vzorků. Tento produkt je dodáván v dehydratované formě a je určen pro přípravu hotových kultivačních médií.

Reagencie "MYCOPLASMA Stabilizer" prodlužuje dobu uchovávání mykoplazmat při zamrazení na - 20°C (+/- 2°C) v UMMt (2 ml) nebo UMMt (3 ml) médiu.

MYCOSCREEN Plus byl vytvořen pro detekci a rozlišení Ureaplasma urealyticum (U.u.) a Mycoplasma hominis (M.h.) v klinických vzorcích.

Mycosel agar je vysoce selektivní medium určené izolaci dermatofytů a dalších patogenních mikromycet ze vzorků masivně kontaminovaných průvodní mikroflórou.

Mycosel agar je vysoce selektivní medium určené izolaci dermatofytů a dalších patogenních mikromycet ze vzorků masivně kontaminovaných průvodní mikroflórou.

Antibiotické disky jsou papírové disky se speciálními vlastnostmi, které jsou impregnovány antibiotiky a používají se pro testování dle Kirby-Bauer metody stanovení antibiotické citlivosti.

Rychlý imunochromatografický kazetový test umožňující kvalitativní detekci antigenu SARS-CoV-2 z nazofaryngeálního nebo orofaryngeálního výtěru.

Rychlý imunochromatografický kazetový test umožňující kvalitativní detekci protilátek proti koronaviru (COVID-19) z plné krve, kapilární krve, séra nebo plasmy.

Rychlý imunochromatografický kazetový test umožňující kvalitativní detekci protilátek proti koronaviru (COVID-19) z plné krve, kapilární krve, séra nebo plasmy.

Antibiotické disky jsou papírové disky se speciálními vlastnostmi, které jsou impregnovány antibiotiky a používají se pro testování dle Kirby-Bauer metody stanovení antibiotické citlivosti.

Antibiotické disky jsou papírové disky se speciálními vlastnostmi, které jsou impregnovány antibiotiky a používají se pro testování dle Kirby-Bauer metody stanovení antibiotické citlivosti.

MIC Test stripy jsou určeny pro kvantitativní stanovení minimální inhibiční koncentrace (MIC) antimikrobiálních látek proti mikroorganismům a pro detekci mechanismů rezistence.